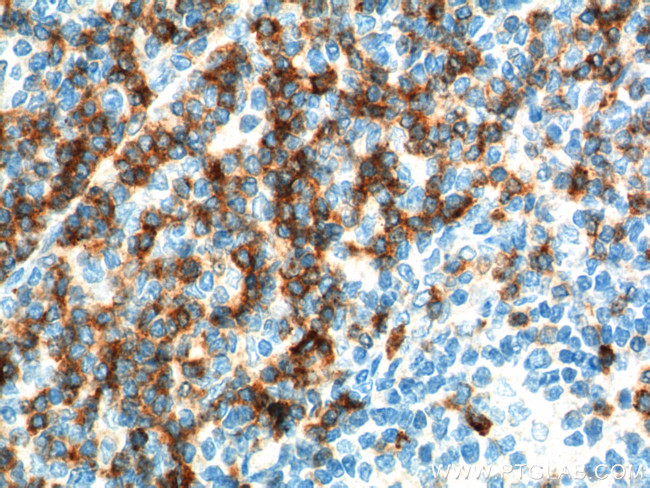
CD7 Antibody in Immunohistochemistry (Paraffin) (IHC (P))

Search
Proteintech
CD7 Polyclonal Antibody
{{$productOrderCtrl.translations['antibody.pdp.commerceCard.promotion.promotions']}}
{{$productOrderCtrl.translations['antibody.pdp.commerceCard.promotion.viewpromo']}}
{{$productOrderCtrl.translations['antibody.pdp.commerceCard.promotion.promocode']}}: {{promo.promoCode}} {{promo.promoTitle}} {{promo.promoDescription}}. {{$productOrderCtrl.translations['antibody.pdp.commerceCard.promotion.learnmore']}}
产品信息
11320-1-AP
种属反应
宿主/亚型
分类
类型
抗原
偶联物
形式
浓度
纯化类型
保存液
内含物
保存条件
运输条件
产品详细信息
Immunogen sequence: MAGPPRLLL LPLLLALARG LPGALAAQEV QQSPHCTTVP VGASVNITCS TSGGLRGIYL RQLGPQPQDI IYYEDGVVPT TDRRFRGRID FSGSQDNLTI TMHRLQLSDT GTYTCQAITE VNVYGSGTLV LVTEEQSQGW HRCSDAPPRA SALPAPPTGS ALPDPQTASA LPDPPAASAL PAALAVISFL LGLGLGVACV LARTQIKKLC SWRDKNSAAC VVYEDMSHSR CNTLSSPNQY Q (1-240 aa encoded by BC009293)
靶标信息
CD7, also known as gp40 or Leu9, is a 40 kDa receptor and member of the immunoglobulin gene superfamily. It features an N-terminal region (amino acids 1-107) that is highly homologous to Ig kappa light chains, while its carboxyl-terminal region is proline-rich, forming a stalk from which the Ig domain projects. CD7 is prominently expressed on the majority of immature and mature T lymphocytes, as well as T cell leukemias. It is also found on natural killer cells, a small subpopulation of normal B cells, and malignant B cells. CD7 plays a crucial role in modulating immune cell activity. Cross-linking of surface CD7 enhances T cell and NK cell functions, as evidenced by increased calcium flux, expression of adhesion molecules, cytokine secretion, and proliferation. CD7 directly associates with phosphoinositol 3-kinase, and its ligation induces the production of D-3 phosphoinositides and tyrosine phosphorylation. The expression of CD7 is an important marker in leukemia diagnostics, highlighting its significance in both normal immune function and disease states.
仅用于科研。不用于诊断过程。未经明确授权不得转售。
篇参考文献 (0)
生物信息学
蛋白别名: CD7; CD7 antigen (p41); GP40; p41 protein; T-cell antigen CD7; T-cell leukemia antigen; T-cell surface antigen Leu-9; TP41
基因别名: CD7; GP40; LEU-9; Tp40; TP41
UniProt ID: (Human) P09564
Entrez Gene ID: (Human) 924